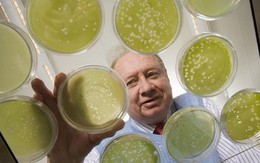
​Phát hiện virus ở họng làm giảm trí tuệ

TT - “Anh tôi sinh ở miền Bắc, nhưng đến giờ vẫn nằm dưới đất lạnh phương Nam. Nhiều lượt cha tôi đã tìm anh, rồi đến anh chị em tôi đi mà đến giờ vẫn chưa thể đưa anh về mảnh đất quê nhà. Có những lần tưởng gần chắc chắn rồi, cả nhà tôi đã vào đón anh về, thế mà...” - cựu quân nhân Đinh Văn Hiển nghèn nghẹn kể về người anh liệt sĩ Đinh Văn Dự của mình.


TT - “Sang những năm thập niên 2010, chúng tôi tưởng chừng đã tuyệt vọng. Anh tôi ra đi như vậy là cả 60 năm rồi. Sông kia bồi lở, lũ lên lũ xuống, tàu bè ngược xuôi mỗi ngày, liệu xương cốt anh có còn gì hay không?”. Bồi hồi nhìn tấm di ảnh đã ố vàng của anh là liệt sĩ Phạm Vũ Biên, ông Duy tâm sự trong lúc người lớn trong gia đình sức tàn lực kiệt, thì con cái ông, tức các cháu liệt sĩ Biên, lại tiếp tục cuộc tìm kiếm.


